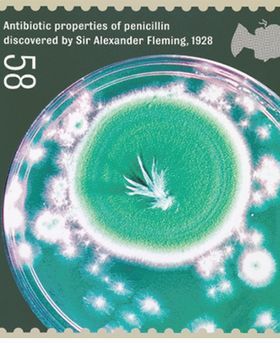
A postage stamp image with penicillin mold in a petri dish. Reading:

Fleming Prize: a short history
The Fleming Prize Lecture is awarded annually to an early career researcher who has achieved an outstanding research record within 12 years of being awarded their PhD. The award was first established in 1976 and named after Alexander Fleming, co-founder of the Microbiology Society (previously known as the Society of General Microbiology), member and its first President (1945-1947).
Alexander Fleming was critically acclaimed as one of the pioneers of modern medicine. He was awarded the Nobel Prize in 1945 alongside Ernst Boris Chain and Sir Howard Walter Florey for the discovery of penicillin and its curative effect in various infectious diseases.
Establishing the Fleming Prize Lecture – a short history
The Fleming Prize Lecture was established after founding member Professor Howard Rogers, suggested a Prize Lecture should be established to recognize the work of early career microbiologists.
Professor Rogers originally suggested that the award should be named after Alik Isaacs, who co-discovered interferon alongside Jean Lidenmann. However, it was later decided following a suggestion from the Society’s first overseas member Roger Stainer, that the award should be named after Alexander Fleming, co-founder of the Society, member and its first President (1945-1947).

Pictured far left: A young Alexander Fleming (1881-1955) in his laboratory at St Mary's Hospital, Paddington, London, in 19O9. St Mary’s Hospital Medical School, Science Photo Library
Pictured right: Howard Rogers (1918-1990), one of the original members of SGM and the instigator of the SGM Fleming Award. SGM
Since the award was instituted, 44 early career microbiologists have been awarded the Fleming Prize and many of them have gone on to achieve distinguished careers, honours and in one case (Paul Nurse) a Nobel Prize.